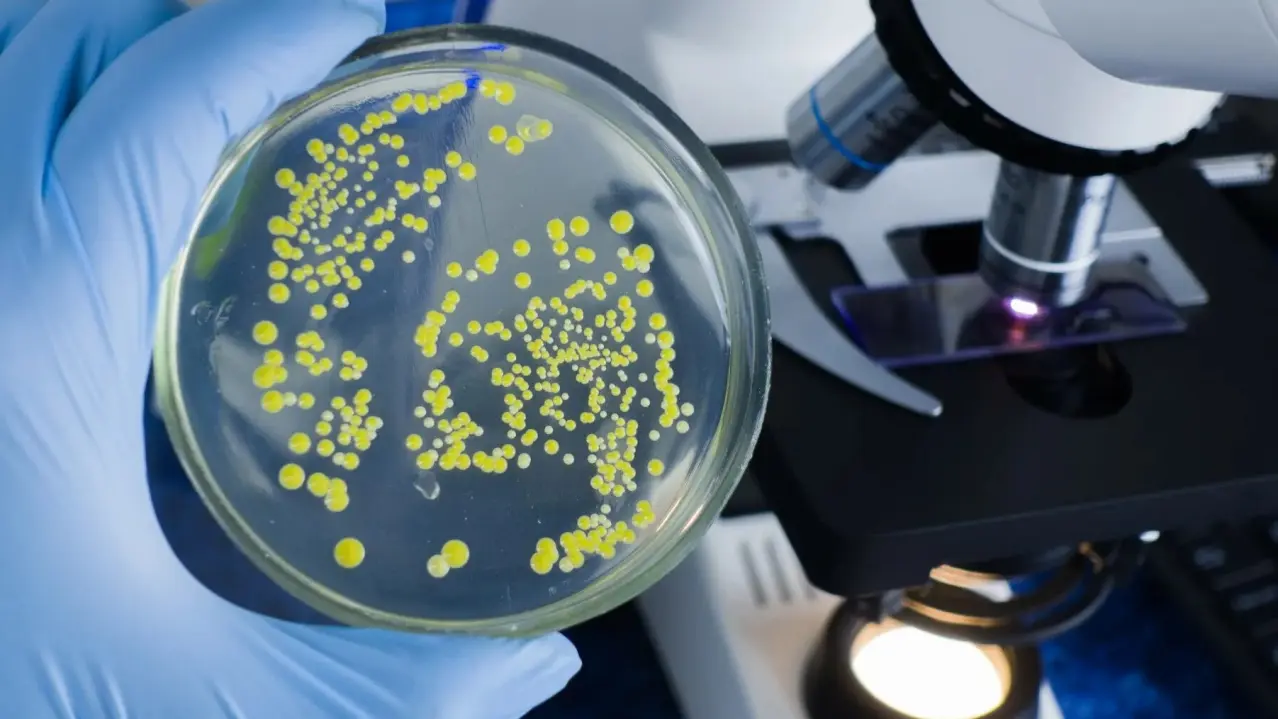

Окуу программасы жөнүндө
Программа биологиялык жана жаратылышты коргоо технологиялары, биология жана адам экологиясы жаатындагы илимий-изилдөө жана практикалык маселелерди чечүүчү атаандаштыкка жөндөмдүү жогорку квалификациялуу адистерди даярдоого багытталган. Бүтүрүүчүлөр тирүү табиятты жана анын компоненттерин изилдөөгө, айлана-чөйрөнү биологиялык көзөмөлдөөгө, лабораторияларда, илимий-изилдөө борборлорунда, медициналык-генетикалык кеңеш берүү мекемелеринде, соттук-медициналык экспертиза бюросунда биохимиялык изилдөөлөрдү жүргүзүүгө мүмкүндүк берген негизги биологиялык билимдерге ээ болушат. Билим берүү программасы беш профиль боюнча ишке ашырылат: биохимия, биоэкология, генетика, зоология, микробиология.